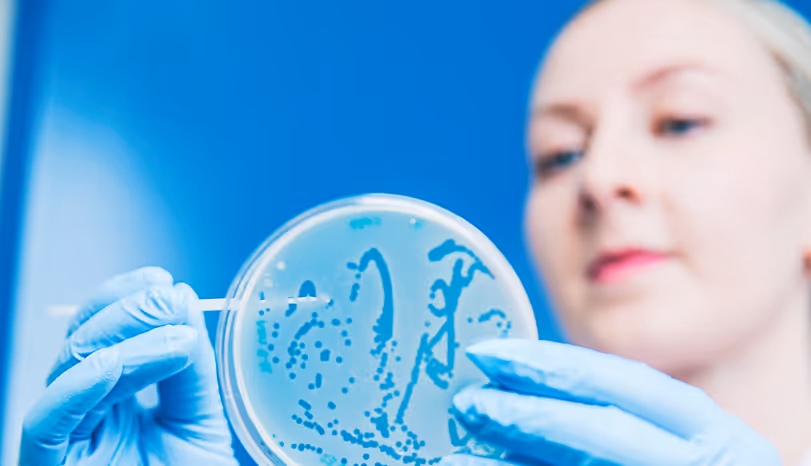
Phage Lab Services

Phage Software & Services
Phagenomics Core
Phagenomics Core streamlines phage genome assembly and annotation, automating complex workflows for fast, consistent, and accurate results.
Boost your projects with the easy-to-use, no-code tool – choose the license that fits you best: Free or Pro.



Phagenomics BatchQC
Phagenomics BatchQC is a GMP-compatible platform for bacteriophage manufacturing. BatchQC automates the verification of genome integrity, contamination detection, and regulatory reporting across production tiers.
Built to meet FDA 21 CFR Part 11, ALCOA+, and GAMP 5 standards, providing full data traceability, secure EU-based infrastructure, and an easily scalable solution with intuitive user interface.


Modular Phage Solutions, Tailored to Your Needs
Our provision pipeline is designed for flexibility. You can move through the entire journey with us or simply choose the stage that matches your current needs. Wherever you join in, you gain reliable support and expertise.
Paving the Way in Phage Solutions to Combat AMR and Enhance Biosafety
At PrecisionPhage, we pride ourselves on groundbreaking research and innovative solutions that drive success in biotechnology. Our commitment to excellence has established us as a trusted partner in the industry.

Combating AMR Superbugs with Phage Technologies
Antimicrobial resistance (AMR) is one of the greatest global health challenges of our time. Each year, infections caused by resistant bacteria lead to longer hospital stays, higher medical costs, and increased mortality.
Humanity urgently needs new ways to fight these pathogens — and bacteriophages offer a powerful alternative, as they:
Target bacteria with precision, including strains resistant to conventional antibiotics.
Work synergistically with antibiotics, enhancing existing treatments rather than replacing them.
Evolve alongside bacteria, maintaining effectiveness even as resistance emerges.


Customer testimonials
We are lucky to be trusted by top brands around the world.